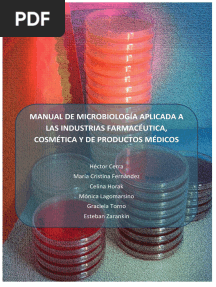

function cn(e,t){var n=e+t;return n<=0?0:Math.round(e/n*100)}% нашли этот документ полезным
Загрузка

Mordeduras de serpientes en la Amazonía ecuatoriana
Добавлено lopeju

Why-Apes-Look-Like-People-by Julius Lester
Добавлено lopeju

Analisis Farmaceutico Libros de Catedra PDF
Добавлено lopeju

Current Technology For The Industrial Manufacture of Snake Antivenoms
Добавлено lopeju
Manual-Microbiologia-Aplicada Industria Farmacéutica PDF
Добавлено lopeju